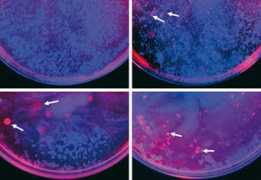
Tehrany

First names for Tehrany
- Hamid Tehrany 6
- Mohammad Tehrany 5
- Iman Tehrany 4
- Hassan Tehrany 4
- Hamed Tehrany 4
- Hadi Tehrany 4
- Payam Tehrany 3
- Naser Tehrany 3
- Mohsen Tehrany 3
- Amir Tehrany 3
- Yalda Tehrany 2
- Soheil Tehrany 2
- Siyavash Tehrany 2
- Sina Tehrany 2
- Shima Tehrany 2
- Shahram Tehrany 2
- Sasan Tehrany 2
- Sara Tehrany 2
- Saman Tehrany 2
- Sahar Tehrany 2
- Saeid Tehrany 2
- Saeed Tehrany 2
- Sadegh Tehrany 2
- Reza Tehrany 2
- Razy Tehrany 2
- Ramin Tehrany 2
- Pedram Tehrany 2
- Omid Tehrany 2
- Nima Tehrany 2
- Nicole Tehrany 2
- Nazanin Tehrany 2
- Navid Tehrany 2
- Nafas Tehrany 2
- Mohamad Tehrany 2
- Moein Tehrany 2
- Mitra Tehrany 2
- Milad Tehrany 2
- Mehrdad Tehrany 2
- Mehdi Tehrany 2
- Maryam Tehrany 2
- Kourosh Tehrany 2
- Kianush Tehrany 2
- Kaveh Tehrany 2
- Kamyar Tehrany 2
- Kambiz Tehrany 2
- Irany Tehrany 2
- Hijran Tehrany 2
- Hediyeh Tehrany 2
- Hany Tehrany 2
- Hanieh Tehrany 2
- Hamidss Tehrany 2
- Ghazal Tehrany 2
- Farhad Tehrany 2
- Elad Tehrany 2
- Behnam Tehrany 2
- Azita Tehrany 2
- Atousa Tehrany 2
- Ashkan Tehrany 2
- Armin Tehrany 2
- Arian Tehrany 2
- Arash Tehrany 2
- Ali Tehrany 2
- Alireza Tehrany 2
- Zaman Tehrany
- Yeganeh Tehrany
- Yasiin Tehrany
- Yashar Tehrany
- Vahid Tehrany
- Tom Tehrany
- Tayebeh Tehrany
- Taher Tehrany
- Taha Tehrany
- Tabasom Tehrany
- Soroush Tehrany
- Sorosh Tehrany
- Somila Tehrany
- Soheila Tehrany
- Soha Tehrany
- Siroos Tehrany
- Sima Tehrany
- Siamak Tehrany
- Shirin Tehrany
- Shervin Tehrany
- Shdy Tehrany
- Shayan Tehrany
- Shahyad Tehrany
- Shahab Tehrany
- Shabnam Tehrany
- Seyed Tehrany
- Setareh Tehrany
- Sepehr Tehrany
- Seena Tehrany
- Sayeh Tehrany
- Sam Tehrany
- Sama Tehrany
- Samar Tehrany
- Sajad Tehrany
- Saied Tehrany
- Safa Tehrany
- Saeedeh Tehrany
- Sadra Tehrany
- Romina Tehrany
- Raheleh Tehrany
- Raha Tehrany
- Radman Tehrany
- Puya Tehrany
- Poya Tehrany
- Pooya Tehrany
- Pierre Tehrany
- Peyman Tehrany
- Peymam Tehrany
- Pejman Tehrany
- Parsa Tehrany
- Parmida Tehrany
- Parasto Tehrany
- Omhidar Tehrany
- Nysa Tehrany
- Nina Tehrany
- Niki Tehrany
- Nick Tehrany
- Neda Tehrany
- Nasim Tehrany
- Nadia Tehrany
- Mozhgan Tehrany
- Mostefa Tehrany
- Mostafa Tehrany
- Morteza Tehrany
- Mina Tehrany
- Merida Tehrany
- Mehran Tehrany
- Mehdy Tehrany
- Maziar Tehrany
- Masoud Tehrany
- Masih Tehrany
- Marjaneh Tehrany
- Mansoureh Tehrany
- Mahya Tehrany
- Mahyar Tehrany
- Mahtta Tehrany
- Mahshid Tehrany
- Mahsa Tehrany
- Mahdi Tehrany
- Mahdieh Tehrany
- Mahbobe Tehrany
- Maha Tehrany
- Mahan Tehrany
- Lital Tehrany
- Lida Tehrany
- Leila Tehrany
- Ladan Tehrany
- Kyan Tehrany
- Kathy Tehrany
- Kathleen Tehrany
- Katayoun Tehrany
- Karen Tehrany
- Kamran Tehrany
- Javad Tehrany
- Hossein Tehrany
- Hoory Tehrany
- Hiva Tehrany
- Fredy Tehrany
- Fereshte Tehrany
- Fateme Tehrany
- Fatemeh Tehrany
- Farzin Tehrany
- Farzaneh Tehrany
- Fariba Tehrany
- Farahnaz Tehrany
- Elnaz Tehrany
- Elmira Tehrany
- Ehsan Tehrany
- Davood Tehrany
- Darya Tehrany
- Danoosh Tehrany
- Daniyal Tehrany
- Curush Tehrany
- Borhan Tehrany
- Bita Tehrany
- Bijan Tehrany
- Ben Tehrany
- Behzad Tehrany
- Behrad Tehrany
- Behnaz Tehrany
- Bardia Tehrany
- Barbod Tehrany
- Baran Tehrany
- Balen Tehrany
- Bahram Tehrany
- Bahar Tehrany
- Bahador Tehrany
- Azade Tehrany
- Atra Tehrany
- Atosa Tehrany
- Atenaa Tehrany
- Asieh Tehrany
- Aryan Tehrany
- Aryamehr Tehrany
- Artin Tehrany
- Arsh Tehrany
- Arshiya Tehrany
- Arsham Tehrany
- Armita Tehrany
- Arman Tehrany
- Ariyan Tehrany
- Aria Tehrany
- Arezu Tehrany
- Arezou Tehrany
- Anna Tehrany
- Amo Tehrany
- Ahmad Tehrany
- Afsaneh Tehrany
- Adrina Tehrany
Typos & Misspells
tehrnay, therany, terhany, tehran, tehranya, tehrsny, teheany, ttehrany, tehranye, tehranyi, tehranyo, tehranny
Top Images for Tehrany

Similar Names
Mehrany